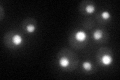
YNL123W
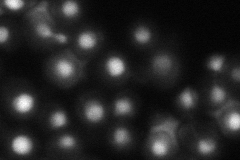
YNL123W
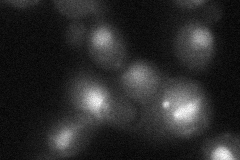
YNL123W

View description
Serine protease and general molecular chaperone; involved in response to heat stress and promotion of apoptosis; may contribute to lipid homeostasis; sequence similarity to the mammalian Omi/HtrA2 family of serine proteases
Localization:
Intensity:
Fold change:
Significance:
-
C’ GFP library in SD
nucleus48.62 -
N' NOP1pr-GFP in SD

nucleus124.219 -
N' TEF2pr-mCherry in SD

nucleus,nucleolus133.565 -
N' NATIVEpr-GFP in SD
nucleus66.6058 -
N' TEF2pr-VC and Cyto-VN in SD
nucleus,nucleolus39.0866 -
C’ GFP library in SD+DTT

nucleus29.30.6Yes -
C’ GFP library in SD+H2O2

nucleus52.011.06No -
C’ GFP library in Starvation Media

nucleus24.40.5Yes -
C’ GFP library on the background of Pup2-DaMP

N/A -
C’ GFP library on the background of CCT mutant

N/A0N/AYes
